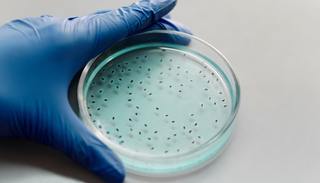

文|动脉网
2020年8月,全球领先的微生态制药企业Seres Therapeutics的拳头产品SER-109在几经周折后,终于取得了显著降低复发性艰难梭菌感染(rCDI)复发几率的III期临床试验结果。这家从美国国家微 物组计划宣布后的投融资热浪中跑出来的微生态制药第一股,股价应声而涨许多天。
而SER-109的好消息也再一次提振了资本对国内微生态制药赛道的信心,几个月之后,未知君、知易生物、慕恩生物等国内明星微生态制药企业相继完成亿元级的新一轮融资,赛道投资门槛不断刷出新高之下所吸引到的,是红杉资本、君联资本、春华资本等顶级投资机构。
两个月前,Seres Therapeutics以5.25亿美元的总价把SER-109在美国和加拿大的商业化权益转让给了雀巢健康科学,全球首款上市的微生态药物呼之欲出。
国内方面,根据美国FDA对外披露的数据,未知君的XBI-302拿到了美国FDA(后简称FDA)在亚洲批准的首个粪菌移植(FMT)药物临床试验批准(后简称IND),临床试验启动在即,国内菌群制药行业走到了商业化的重要里程碑。
与此同时,知易生物的在研管线SK08即将由中华医学会消化病学主委陈旻湖教授牵头开展针对肠易激综合征的II期临床试验;慕恩生物在6月宣布B+轮融资时也表示,新募集的资金将用于推进两个创新性活菌药物的临床试验。
7月初,未知君面向深圳18~40岁健康人的有偿粪菌捐献招募登上了微博热搜。对于符合条件的捐赠者,未知君在其每次捐赠时给予300元补助,每月最多可以捐赠22次。也就是说,有人可能因为捐献粪菌,每个月增收6600元。“反响完全超出预期,”未知君工作人员告诉动脉网,“我们的几个工作微信号都被涌进来的好友申请挤爆。”
尽管按照国际现行的供体筛选标准,真正能够成为微生态药物原料供体的幸运儿很少,但这并不妨碍粪便带着人们的好奇和厌弃,从1700多年前葛洪《肘后备急要 》里的一剂黄汤,蜕变成写入临床处方的一粒胶囊或者一袋粉末,完成了功能和价值的进击,而微生态制药产业的底层逻辑也随之发生根本变革。
“有味道”的黑科技落地临床
粪菌移植顾名思义,是指将健康个体粪便中的功能菌落,移植到患者胃肠道内,重建新的肠道菌群,实现肠道及肠道外疾病的治疗。
肠道微生物是人体微生态中体量最大,也最错综复杂的体系,由一定比例的有益菌群、中性菌群和有害菌群组成。当肠道菌群结构失衡,人体健康状况则可能遭到破坏。研究表明,肠道菌群与某些疾病之间存在联系,具体包括消化系统疾病、代谢类疾病、免疫系统疾病以及神经系统疾病等。

部分肠道菌群与疾病关系(数据来源:动脉网根据公开资料整理)
其中比较热门的是消化系统和内分泌系统疾病,例如 前微生态药物研发最为成熟的像艰难梭状杆菌感染、炎症性肠病(包括溃疡性结肠炎和克罗恩病)、肠易激综合征、便秘等肠道疾病,肥胖、2 型糖尿病、代谢综合征等代谢病。据统计,截至2019年末,临床研究注册网站Clinical Trials上注册的肠道微生态药物临床研究已经有近300项,覆盖超过50个病种。为数最多的临床研究集中在艰难梭状杆菌感染,其次是溃疡性结肠炎和肠易激综合征。
此外,随着肠道微生态与疾病关系研究的深入,肠-肾轴、肠-心轴、肠-脑轴等路径机理不断浮出水面, 闭症、抑郁症、肿瘤、脂肪肝等范围更广的疾病陆续被纳入肠道微生态制药的研究范畴。
正是有了这些科学研究做支撑,过去10年间,菌群移植进入临床治疗的可能性得到了广泛认可。2013 年,菌群移植治疗复发性艰难梭状杆菌感染进 了美国 FDA 的治疗指南。4年后,微 物组被克利夫兰医学中 评为了 医学创新之 。在国内,3年前,菌群移植在 州市拥有了收费编码,由此打通作为医疗服务项目落地临床应用的最后一公里。至今已经进入超过10个省市的医疗收费编码系统。
然而,尽管有大量资金涌入,也有Finch、Seres、Vedanta、Rebiotix等企业前仆后继地坚持闯关,微生态制药的真正商业化落地的实质性进展却相对缓慢。“最早期的品种有的消失了,有的进入停滞阶段,目前推进比较快的主要有Rebiotix的2660和Seres的SER109两个品种。”一位从业者告诉动脉网。
这背后的原因,一方面是微生态中菌群与疾病的相互作用机制不够明确,在一定程度上提高了临床试验设计和验证的难度,另一方面是微生态药物作为活体药物的特殊属性,让稳定的安全性、有效性控制成为重要考量。
首先,肠道微生物群落比较复杂,目前科学家对其影响健康的机理、微生物群落间互作的机制、与人体免疫反应的互作机制、导致艰难梭菌感染和抑制艰难梭菌感染的机制,都还处于比较混沌的状态。采用健康人粪便中有限菌群做药,研发者往往并不明确其潜在发挥作用的机制,即不确定究竟是何种微生物在发挥作用,“有时甚至连能够起作用的物种是否存在在微生态药物所选的菌里,都不能确定,”一位从事微生态药物开发多年的研究者向动脉网表示,“与此同时,药物抵达肠道后将以怎样的模型实现定植,也比较难确定。”
其次是生产工艺与传统药企差异明显,其原材料的特殊性,导致在生产过程中的质量监测和检测工作量较大。未知君创始人谭验博士告诉动脉网,微生态药物在生产过程中,一方面需要实时控制杂菌、有害病原体污染,另一方面保证整体菌群的高存活率,从而确保微生态药物的安全性和有效性。而由于微生态制药在全球范围内都还处于从0到1的探索阶段,研发、生产的各个环节几乎无法借力在小分子、大分子药物领域已经相当成熟的外包服务体系,企业自主构建和验证工艺流程的过程,无疑增加了微生态药物开发的门槛和风险。
随着国内外微生态制药企业研发能力的持续演进,两个方面的障碍正不断被突破。“这对所有人来说都是know how的过程。”谭验博士表示,“我们经过了多次生产流程优化,才逐步缩小批次间的差异。获得FDA的IND批件是一个重要的里程碑,但也意味着更多更大的挑战。”他告诉动脉网,除了常规项目外,针对一些美国流行广泛而在中国鲜有的细菌及寄生虫,美国FDA同样会进行严格的审查,为此,未知君做出了大量的策略调整。有意思的是,作为工艺开发的副产品,未知君还构建了一整套符合FDA微生态药物生产要求的生产流程、工艺、质量标准体系。
无独有偶,知易生物历时5年独立完成在GLP安全评价、菌株安全性评价、CMC研究、药理药代等微生态药物产业化关键步骤后,也增加了微生态药物的CRO服务模块,对外提供人体致病栖生菌谱与疾病关系研究、新功能菌株筛选与靶标确定,以及活菌药物研究开发平台服务。
微生物制药成为新风口
政策支持、科研和技术突破、资本促进之下,全球微生态药物产业自2016年前后开始进入发展的快车道。2007年,美国启动了 类微 物组计划。随后,欧盟、加拿 、法国、澳 利亚等国分别启动国家微 物组计划。2016年,美国也斥资数亿美元启动国家微 物组计划。
在这些国家微 物计划的推动下,Evelo、Finch、Seres、Rebiotix等一大批后来的微生物制药明星企业涌现出来。据不完全统计,全球微生态制药公司已经超过了50家,其中质地比较好的30余家已经累计吸金超过30亿美 。
这些创业公司中,有的从事微生物自身结构蛋白研究,例如Second Genome,有的从事单菌株研究,以4D、Evelo为代表,而更多的则从事多菌种混合研究,代表企业包括Seres、Finch、Rebiotix等。而由于Seres和Rebiotix双双将治疗艰难梭状杆菌感染的药物推进到III期临床试验,多菌种混合的微生态药物也成为产业化进展最快的分支。
有分析人士预测,到2026年,全球微生态药物市场空间有望达到100亿美元,并在未来保持持续增长。
在这个过程中,微生态药物也引来了罗氏、强生等跨国制药巨头的布局。

部分MNC的微生态制药布局(数据来源:动脉网根据公开资料整理)
与创业企业多从事消化道疾病、代谢疾病的微生态药物开发不同,这些跨国药企将关注的焦点放在了更热门的领域,微生态药物成为了他们角力肿瘤免疫疗法的一个重要工具。
例如,2016年,辉瑞、罗 联合投资了Second Genome,资金被用于拓展微生物发现平台,并推进微生物组介导靶点的小分子抑制剂研究;2017年,强 投资BiomX,后者通过定制噬菌体来开展癌症、肝脏疾病和IBD等疾病治疗研究。而百时美施贵宝投资Vedanta、默沙东牵手Evelo,则旨在探索通过微生态药物与PD-1联用,来提升后者对于癌症患者的疗效。此外,阿斯利康也曾以2000万美 投资Seres,共同探索用菌群提高肿瘤免疫疗法疗效的方法。不过遗憾的是,阿斯利康当时落子的并不是眼下即将实现商业化的SER-109。
在国内,专门从事微生物制药的公司并不多。动脉网梳理发现,真正属于严格意义上的微生物制药公司目前只有4家,但他们都已经完成了数千万,甚至上亿元融资。换言之,国内微生态制药行业正处于快速发展的起步阶段。

国内主要的微生态制药企业及融资情况(数据来源:动脉橙数据库)
进一步观察可以看出,4家微生态制药企业各有所长。未知君是国内领先的专注于肠道微生物治疗的 AI 制药公司。9月初,未知君宣布其正在研发的粪菌移植药物XBI-302获得了FDA的IND批准,这是国内微生态制药企业在国际微生态制药赛道上走得最远的一次。
在一定程度上,XBI-302的IND批件标志着中国的制药企业正式开拓出一条国内微生态药物向美国FDA递交审批的完整路径,这是实现粪菌移植从治疗形式向药物形态转化的关键步骤。
实际上,尽管已经有相对丰富的FDA审批粪菌移植药物申请先例可供参考,由于许多安全性审查项目的侧重点不同,其中的大量细则对于国内微生态制药企业而言仍是全新的挑战。而XBI-302被成功推进到临床试验阶段,对于国内微生态制药企业如何做供体筛选、原料质量控制、生产工艺和平台优化等,提供了关键的样本。
而最早成 的知易 物,主要从事新 代益 菌与活菌 物药的临床研究与开发,于2019年11 将在研管线SK08推进到国内I期临床试验;慕恩生物和承葛生物侧重技术服务平台建设,前者致力于构建微 物资源发掘与药品开发平台,后者则主要探索建立精准化菌群移植治疗平台。
数字化的菌株库能力或成兵家必争之地
动脉网注意到,最近一年来,许多新的初创公司涌入微生物制药领域,但几乎无一能够快速做出成绩。究其原因,一方面,微生态药物开发必须建立在丰富的菌株库之上,而菌株库的建立无法一蹴而就,另一方面,基于完善菌株库做开发更是一项依托长期积累的计算、临床、药学能力的复合型工作。
活菌药物开发相比于同阶段的大分子和小分子药,最大的区别在于绝大多数进入临床的活体生物药采用的是天然菌株,这就需要强大的菌群库。2012年,美国 家 营利性的菌库OpenBiome成 ,并在全球掀起了建 菌群库的热潮。
据不完全统计, 前全球规模性菌库已经多达20余家,比较知名的除了OpenBiome,还有法国圣安东尼奥医院菌群库、荷兰莱顿 学医学中 的菌群库、英国Taymount医疗中 菌群库、德国科隆 学医院菌群库、中华粪菌库等。
谭验博士告诉动脉网,未知君作为国内成立稍晚的微生态制药企业,却能率先拿下FDA的IND批件,离不开强大的菌群库和知识库能力。
据了解,未知君整合公共数据集、企业自有的健康个体及各适应症患者治疗前后的海量菌群数据,搭建并持续沉淀未知君自有的知识库,形成了全球覆盖面最广的肠道菌群知识库之一。后者包含超过5,000个跨健康与疾病群体个体数据、超过8,000条宿主基因与肠道微生物关联数据和超过34万条微生物与疾病关联数据,并且对所有数据及其对应的样本均经过统一流程的重处理和有效整合。
“基于持续沉淀的数据库,我们通过以肠道微生物为生物标志物的预测模型,对于肿瘤病人接受PD-1治疗的预测精度达到了国际先进水平。”谭验博士表示。
在海量菌群库的基础上,精准识别菌群功能、配方入药,无疑需要借助 智能结合 物信息分析的 法。
据了解,未知君拥有国际领先的生信分析能力,能够对数据价值实现快速挖掘与深入洞察。具体而言,现阶段未知君的Xstrain、MSEA两项生物信息领域的技术处于全球前列。
其中,Xstrain是第一个从宏基因组样本里面直接解析菌株组成及各菌株对应的基因的工具,相比于传统的菌株分析方法,不仅提升了检测灵敏度,同时可以以功能信息来辅导对菌株的筛选。
而MSEA则是全球第一款通过文本挖掘从差异菌预测宿主功能改变的工具,开创性地从菌群组成的改变直接预测宿主基因层面的调控,有助于增进对微生物-宿主相互关系的理解和微生物生理作用的解读。
不过,微生态制药作为一项鲜有参照的全新尝试,有许多细节有待优化,而这些优化对于任何团队而言,都是不小的挑战。例如,微生态药物常以菌液形式出现,随制随用、不便于保存,如果能以胶囊形态保存,则可以极大提高时效性和可及性,但胶囊中的微生态药物如何制剂、如何确保菌株活性,都需要反复尝试才能找到最优解。
据了解,未知君正在探索活菌微球等微生态高端制剂,探索利用自主技术,开发一种能够靶向肠道的活菌微球制剂,从而精准递送肠道微生物的活性与效能。
也就是说,经过数年发展,微生态药物行业很快会交出首份答卷,但要交出满意答卷,还需要整个行业共同努力,做大量微创新。
